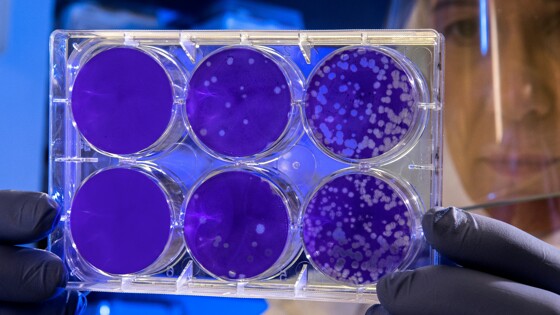

Генетический анализ эмбрионов при ЭКО: современные методы диагностики для успешного планирования здоровой беременности
Генетическое тестирование эмбрионов позволяет выявить хромосомные аномалии до переноса. Современные методы диагностики повышают вероятность успешной беременности при ЭКО до 70%.
Генетическое тестирование перед имплантацией творит настоящие чудеса. На молекулярном уровне специалисты способны определить потенциальные риски и отклонения, выбирая самый перспективный эмбрион для успешной беременности. Каждый день эта технология дарит надежду тысячам будущих родителей.
За последнее десятилетие точность и доступность генетической диагностики значительно выросли. Современные методы анализа позволяют исследовать все хромосомы эмбриона и выявлять даже микроскопические изменения в структуре ДНК. Это революционным образом изменило подход к планированию семьи.
Когда генетический анализ становится необходимостью
Существует несколько ключевых ситуаций, когда генетическое тестирование эмбрионов особенно рекомендовано:
- Возраст матери старше 35 лет;
- Наличие наследственных заболеваний в семье;
- Предыдущие неудачные попытки ЭКО;
- История выкидышей;
- Мужской фактор бесплодия.
Принятие решения о проведении генетического анализа – это важный шаг на пути к родительству, требующий тщательного обсуждения с врачом.
Современные методы генетической диагностики
Биопсия трофэктодермы позволяет безопасно получить клетки для анализа на 5-6 день развития эмбриона. Специалисты аккуратно забирают несколько клеток внешнего слоя бластоцисты, не затрагивая внутреннюю клеточную массу, из которой формируется плод. В лаборатории при этом цена на генетический анализ эмбриона при ЭКО вполне оправдана высокой точностью исследования.
Существующие технологии позволяют провести всесторонний анализ генетического материала:
- Определение количества хромосом (кариотипирование);
- Поиск специфических мутаций;
- Выявление структурных хромосомных аномалий;
- Определение пола эмбриона.
После получения результатов врач подробно объясняет их значение и помогает принять взвешенное решение.
Результаты и перспективы технологии
Преимплантационная генетическая диагностика значительно повышает шансы на успешную беременность. По статистике, вероятность наступления беременности после переноса генетически здорового эмбриона достигает 60-70%. При этом существенно снижается риск самопроизвольного прерывания беременности и рождения ребенка с хромосомными аномалиями.
Будущее генетического тестирования связано с развитием технологий секвенирования нового поколения. Это позволит получать еще более детальную информацию о здоровье эмбриона и делать более точные прогнозы по развитию беременности.
На пути к осознанному родительству
Генетическое тестирование эмбрионов – это не просто медицинская процедура, а важный шаг к осознанному родительству. Оно дает будущим родителям уверенность в здоровье их малыша и помогает принимать информированные решения на пути к созданию семьи.
Эта технология продолжает совершенствоваться, открывая новые возможности для будущих родителей. Главное – помнить, что каждая ситуация индивидуальна, и решение о проведении генетического анализа должно приниматься совместно с командой специалистов.